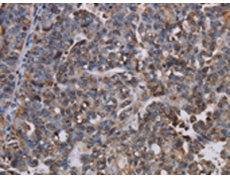
一抗

|
Background: |
The protein encoded by this gene belongs to the ERG4/ERG24 family. It localized in the nuclear envelope inner membrane and anchors the lamina and the heterochromatin to the membrane. It may mediate interaction between chromatin and lamin B. Mutations of this gene has been associated with autosomal recessive HEM/Greenberg skeletal dysplasia. Alternative splicing occurs at this locus and two transcript variants encoding the same protein have been identified. |
|
Applications: |
ELISA, WB, IHC |
|
Name of antibody: |
LBR |
|
Immunogen: |
Fusion protein of human LBR |
|
Full name: |
lamin B receptor |
|
Synonyms: |
PHA; LMN2R; TDRD18; DHCR14B |
|
SwissProt: |
Q14739 |
|
ELISA Recommended dilution: |
2000-5000 |
|
IHC positive control: |
Human ovarian cancer |
|
IHC Recommend dilution: |
50-200 |
|
WB Predicted band size: |
71 kDa |
|
WB Positive control: |
Human fetal brain tissue |
|
WB Recommended dilution: |
500-2000 |


 購物車
購物車 幫助
幫助
 021-54845833/15800441009
021-54845833/15800441009